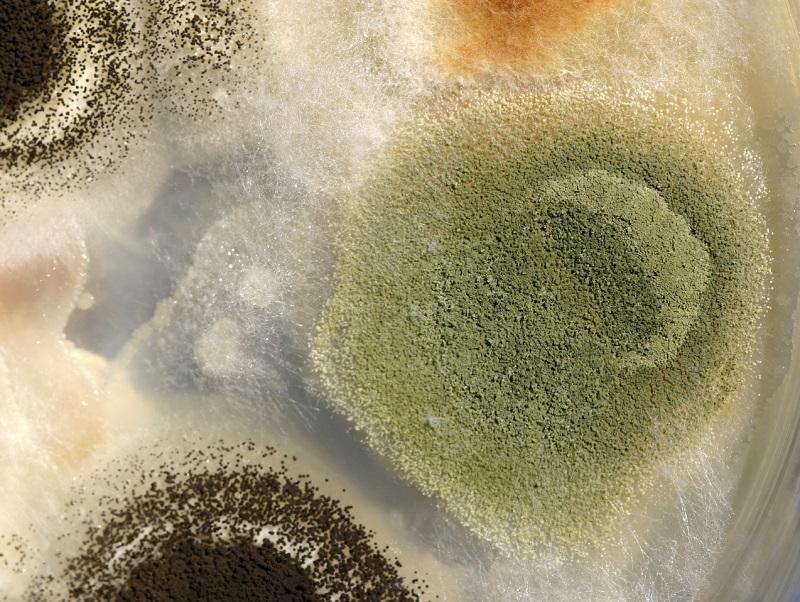

Cómo se contagia la balanitis


La balanitis es una inflamación del glande y el prepucio que causa grandes molestias en los hombres, produciendo además de dolor otros síntomas como enrojecimiento del área y olor fétido, ocasionando gran incomodidad tanto al paciente como a su pareja en el caso de que la haya. Una de las preguntas más frecuentes que se hacen los hombres es cómo se contagia la balanitis, sin embargo la respuesta es variada pues esta inflamación puede producirse por diversas causas. En unComo.com te lo explicamos con más detalle en este artículo.
Síntomas de la balanitis
Identificar los síntomas de la balanitis resulta importante para reconocer rápidamente esta condición y acudir a un urólogo. Esta patología se produce debido a una infección local que puede estar ocasionada por bacterias u hongos, presentando comúnmente síntomas como:
- Enrojecimiento del glande el pacientes circuncidados y del prepucio si no hay circuncisión.
- Dolor en la zona afectada.
- Escozor y comezón.
- Si la infección avanza sin tratamiento se puede presentar supuración de líquido blanquecido y un olor fétido intenso. En este punto se hace imprescindible consultar al urólogo.
Causas de la balanitis: infecciones
La balanitis puede producirse por el contagio de bacterias y hongos que ocasionan la inflamación del glande. El hongo Candida albicans es uno de los detonantes más comunes de la balanitis, el mismo suele vivir en nuestro cuerpo en zonas como la boca o los intestinos sin embargo el debilitamiento del sistema inmune, una mala higiene íntima o el sexo sin protección con una mujer que padezca de candidiasis vaginal puede favorecer la aparición de este hongo en el glande.
Adicionalmente la balanitis también puede presentarse debido al contagio de bacterias de diferentes tipos como el Streptococcus, el Staphylococcus o la sífilis.

Causas de la balanitis: debido a un virus
Además de la presencia de hongos o infecciones, la balanitis también se puede producir debido al contagio de virus de transmisión sexual como el VPH o el herpes genital. Tener sexo siempre con protección, especialmente si existe promiscuidad, es muy importante para evitar el contagio de condiciones que comprometan nuestro bienestar.

Balanitis causada por enfermedades
Algunas enfermedades pueden ser también causantes de la balanitis, por ejemplo:
- Diabetes mal controlada
- Artritis reactiva
- Liquen escleroatrófico
- Psoriasis
- Obesidad mórbida
- Lesiones premalignas de piel
Otras causas de la balanitis
Además de las condiciones mencionadas anteriormente, otras situaciones pueden desencadenar también el padecimiento de balanitis, entre las más comunes están:
- Mala higiene al momento de lavar el pene, especialmente común en pacientes con prepucio. Además de lavar bien la zona es imprescindible retirar adecuadamente todo el jabón.
- Uso de jabones demasiado fuertes que generan irritación en esta delicada zona.
- Aplicar en la zona del pene perfumes o cremas, que pueden irritarla y producir esta condición.
Acudir a un urólogo
Ante los primeros síntomas de balanitis resulta importante acudir a un urólogo para confirmar el diagnóstico y determinar también la causa de esta condición. En nuestros artículos cómo tratar la balanitis y ¿puedo tener sexo con balanitis? te explicamos un poco más acerca de esta patología.

Este artículo es meramente informativo, en unCOMO no tenemos facultad para recetar ningún tratamiento médico ni realizar ningún tipo de diagnóstico. Te invitamos a acudir a un médico en el caso de presentar cualquier tipo de condición o malestar.
Si deseas leer más artículos parecidos a Cómo se contagia la balanitis, te recomendamos que entres en nuestra categoría de Salud de la Familia.